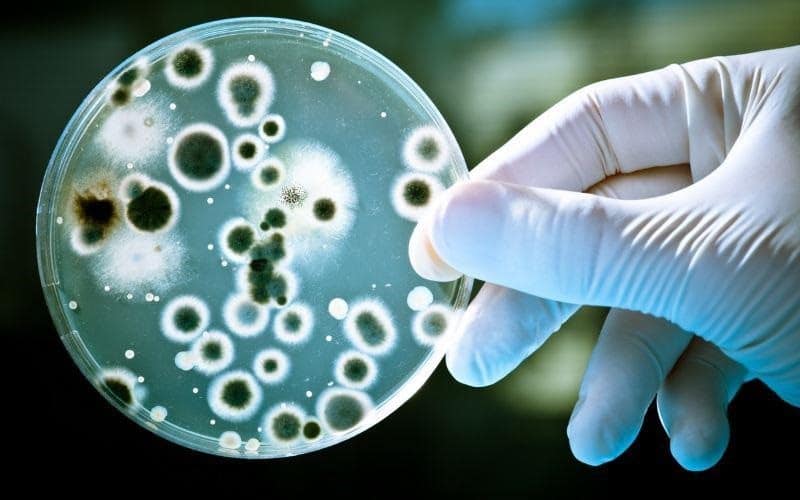
image

Молочница на губах — распространенное заболевание, которое вызывают дрожжевые грибы Candida. Они являются частью естественной микрофлоры человека, но при определенных обстоятельствах могут размножиться и спровоцировать развитие кандидоза. Чаще всего эта болезнь возникает у детей, но также встречается у взрослых и даже пожилых.
Кандида является одноклеточным грибком и имеет около 150 разновидностей. В здоровом организме он не вызывает никаких проблем. Но в некоторых случаях может начаться активное размножение этих грибков. Это приводит к тому, что они видоизменяются и проникают внутрь эпителия слизистой оболочки полости рта. Там грибки интенсивно развиваются и разрушают окружающие ткани, в результате чего появляются неприятные симптомы.
Если не лечить молочницу длительное время, она может перейти в хроническую стадию. И тогда заболевание будет протекать с обострениями в течение долгих месяцев. В этом случае поражение грибком может охватить гортань, пищевод и желудок. Поэтому очень важно выявить кандидоз на раннем этапе и после подтверждения диагноза врачом сразу же начать лечение.
Как развивается молочница
Круглосуточно человека окружает внешняя среда. Она служит своеобразным проводником для различных микроорганизмов, вирусов и грибков, которые, избирая благоприятную среду для проживания, селятся на коже, на слизистых оболочках ротовой полости, носа и горла, кишечника, органах репродуктивной системы. Иммунитет здорового человека успешно сдерживает рост условно-патогенной микрофлоры, к которой относится и Candida.
Но если иммунный барьер ослаб, то грибки начинают проникать в клетки слизистых оболочек и продуцировать опасные ферменты. На поверхности эпителия образуются белые комочки – псевдомицелий, состоящий из патогенов, разрушенных клеток слизистой рта и остатков пищи. Если удалить налет, то слизистая под ним будет выглядеть покрасневшей и воспаленной. Так развивается кандидоз полости рта.
На заметку! Больше половины людей являются носителями грибков. Но они находятся в «спящем» состоянии, не доставляя никаких хлопот. Но под воздействием внешних факторов, например, при снижении иммунитета, во время болезней, при длительном стрессе, они начинают свою активную разрушительную деятельность.
Как выявить болезнь
При подозрении на молочницу губ и ротовой полости диагноз может поставить стоматолог. Но окончательно диагностировать и назначить лечение должен дуэт врачей парадонтолога и гастроэнтеролога. Для этого будет взят мазок на исследование грибковых культур и вида грибка, вызвавшего заболевание. При подозрении, что молочница поразила органы пищеварения, будет назначена эндоскопическая диагностика. В особо сложных случаях при поражении других органов потребуется вмешательство врача-инфекциониста.
Причины возникновения кандидоза во рту
Основная группа риска по возникновению молочницы во рту – это дети первого года жизни. Практически каждый семейный человек сталкивался с этим недугом у собственных детей или хотя бы слышал о нем от родственников. Также от кандидоза во рту страдают и люди старшего поколения – те, кто уже вышел на пенсию. Детей и пожилых людей объединяет несовершенство иммунитета. Только у малышей он еще не заработал в полную силу, а у пожилых людей – ослаб с возрастом.
Причины, способствующие возникновению молочницы в полости рта:
- слабый иммунитет: в силу возраста или некоторых заболеваний, например, ВИЧ-инфекции,
- антибиотики и оральные контрацептивы: их длительный прием вносит дисбаланс в организм и делает его уязвимым к патогенной микрофлоре,
- беременность: гормональные изменения, перестройка обмена вещества зачастую вызывают кандидоз,
- травматические повреждения слизистой во рту: ушибы, сколотые пломбы и плохо подогнанные протезы повреждают ткани, и в них заносится инфекция,
- дефицит витаминов В, С и РР: ведет к ослаблению питания слизистых, развитию стрессовых состояний,
- заболевания: дисбактериоз, диабет, онкология, наркологические проблемы – эти болезни и некоторые способы их лечения (например, лучевая терапия) также провоцируют кандидоз,
- курение.
Интересный факт! По статистике Всемирной организации здравоохранения, каждый 5-ый ребенок в возрасте до 12 месяцев и каждый 10-ый взрослый старше 60 лет перенес кандидоз ротовой полости.
Причины появления
В детском возрасте ей подвержены в основном новорожденные малыши. Ребенок не может пожаловаться на болезненные ощущения, о болезни свидетельствуют повышение температуры, беспокойство, перепады настроения и отказ от пищи.
Согласно статистике, около 60% новорожденных детей переносят молочницу ротовой полости в острой форме. При отсутствии должного лечения грибок распространяется внутрь организма и поражает слизистые внутренних органов пищеварительного тракта, ослабляя иммунитет и вызывая ряд болезненных состояний.
Причинами возникновения кандидоза являются:
- Младенец заражается молочницей от матери, причем это может произойти уже в организме матери в момент прохождения родовых путей. При кормлении грудью также вероятно заражение грудничка грибком.
- Получить возбудителя можно и на приеме в поликлинике или, находясь в родильном отделении, при контакте с носителем.
- Грибок попадает в организм ребенка, если мама не стерилизует бутылочки и соски, позволяет себе облизнуть пустышку и дать её малышу.
- Вызвать заболевание могут плохо обработанные игрушки, соски и пищевые продукты.
- У деток недоношенных, переношенных или перенесших патологические роды, кандидоз появляется крайне часто.
- Частые простуды и инфекционные заболевания на фоне ослабленного иммунитета также способствуют появлению молочницы полости рта.
- При неправильном введении первого прикорма, когда в рационе ребенка появляется много углеводосодержащих продуктов и не хватает кисломолочных – источника полезной микрофлоры, кандидоз не заставит себя долго ждать.
У взрослых сигналом к развитию молочницы на губах является ослабленный иммунитет. К основным факторам возникновения хейлита относятся:
- сахарный диабет и другие тяжелые заболевания (раковые опухоли, гепатиты и прочие),
- ВИЧ-инфицирование (3 человека из 4 больных СПИДом страдают кандидозом),
- послеоперационный период, химиотерапия,
- туберкулез,
- длительное лечение антибиотиками,
- период беременности,
- применение оральных контрацептивов,
- нерегулярная и неправильная чистка зубов,
- травмы губ,
- ношение протезов,
- авитаминоз,
- вредные привычки (курение и алкоголь),
- дисбактериозы разной этимологии,
- кариес.
Получить порцию грибков Кандида можно при поцелуях или питье из одного стакана. При крепком иммунитете болезнь, скорее всего, не разовьется. Нередко кандидоз на губах является спутником герпеса. Наиболее подвержены заболеванию кандидозом жители южных районов с теплым влажным климатом, пожилые люди и женщины детородного возраста.
Как проявляется заболевание у детей
Маленькие дети зачастую не могут сказать о том, что их что-то беспокоит. Поэтому в начале любого заболевания ребенок становится капризным, часто плачет, может появиться вялость и отказ от еды или пустышки. Такие симптомы бывают у детей и при молочнице во рту и, несомненно, должны насторожить родителей.
Характерно появление творожистого белого налета и бляшек, гиперемия и покраснение на языке, горле, внутри щек и губ. Может появиться неприятный запах изо рта и покрасневшие трещинки в уголках губ. Температура до 39⁰С нередко сопровождает этот недуг.
Заражение грибком Candida у детей может произойти несколькими путями:
- через посуду: плохо обработанные пустышки, бутылочки, ложки, кормление из чужой посуды являются фактором риска,
- через предметы обихода,
- в процессе лактации: если кормящая мать заражена грибком или принимает антибиотики,
- во время родов.
Важно! Родителям следует помнить, что нельзя пробовать еду детской ложкой и облизывать пустышку, если она упала – лучше помыть ее специальным средством. У ребенка должна быть своя личная посуда, из которой ест и пьет только он. То же самое можно сказать и про зубную щетку.
Профилактика кандидоза
Оградить себя от грибка можно, улучшив гигиену и усилив иммунитет. Следует соблюдать все правила гигиены, в том числе:
- Пользоваться отдельными щетками, полотенцами;
- Использовать индивидуальные либо мытые столовые приборы и посуду;
- Не употреблять в пищу продукты сомнительного качества, просроченные продукты;
- Овощи и фрукты перед употреблением тщательно мыть в теплой воде;
- По возможности подвергать овощи и фрукты тепловой обработке;
- Мыть руки после контакта с животными, после выхода за пределы квартиры, перед едой.

Пользоваться отдельными полотенцами
Использовать индивидуальные либо мытые столовые приборы и посуду
Не употреблять в пищу продукты сомнительного качества
Не употреблять в пищу просроченные продукты
Овощи и фрукты перед употреблением тщательно мыть в теплой воде
По возможности подвергать овощи и фрукты тепловой обработке
Мыть руки Человек часто совершает движения, связанные с прикосновением к губам, не осознавая этого. Он может делать это во время задумчивости, при нервных состояниях. Постарайтесь отказаться от таких вредных привычек, как обкусывание ногтей, посасывание карандаша. Они также могут стать причиной, по которой грибок попадает в ротовую полость и развивается на поверхности губ.
Особенно тщательно нужно следить за гигиеной ребенка. Малыш не должен брать грязные предметы в рот. Пустышки и соски от бутылочек, из которых он пьет, должны быть постоянно чистыми. Лучше обрабатывать их при помощи пищевой соды. Даже соски матери, кормящей грудью, рекомендуется в умеренных количествах обрабатывать пищевой содой, чтобы снизить вероятность их заражения грибками.
Также важно повысить иммунитет. Сделать это можно следующими способами:
- Начав принимать поливитамины;
- Увеличив дозу аскорбиновой кислоты в ежедневном рационе (содержится в цитрусовых, в некоторых травах и овощах);
- Использовав умеренные процедуры закаливания, такие как контрастный душ, обтирания и т.п.
Если есть системные заболевания, гормональные сбои, от них следует избавиться, иначе они постоянно будут ухудшать иммунитет человека. Также плохо сказываются на защите организма аутоимунные заболевания.
В период после восстановления от молочницы следует отказаться от спиртного, поскольку алкоголь убивает микрофлору желудка и может приводить к росту патогенных грибков.
Если вы курите, рекомендуется бросить эту привычку. Попадание дыма и шлаков, образующихся при сожжении табака, увеличивает скорость развития грибка. В процессе курения опасно и само действие – взятие сигареты в рот. Часто сигареты оказываются ненадлежащего качества, они могут долгое время храниться в кармане, становиться грязными. На них могут скапливаться вредные микроорганизмы, в том числе рода Кандида.
Клиническая картина кандидоза во рту
Стоматологи выделяют 3 типа классификации молочницы ротовой полости. Эти формы учитываются при диагностике (речь о ней пойдет позже).
По сложности течения клиническая картина бывает:
- острая,
- хроническая.
По месту расположения (локализации) кандидозных поражений:
- глоссит: очаги находятся на языке,
- хейлит: поражен эпителий губ,
- стоматит: инфекция локализуется на слизистой щек и неба,
- гингивит: кандидозные бляшки расположены на деснах,
- тонзиллит: грибок распространяется на слизистой глотки.
Клинико-морфологическая картина подразделяется на следующие типы:
- эрозивно-язвенная: часто начинает распространяться с углов губ, где расположены болезненные эрозивные трещинки. Если вовремя не заняться лечением, то поражается внутренняя часть рта. Возникают кандидозные язвочки, которые могут быть покрыты творожистым налетом,
- гиперпластическая: затяжная форма кандидоза. Бляшки сливаются плотную желтоватую пленку, в которой присутствует большое количество фибрина. Ее очень трудно снять со слизистой, а если это удается – то ткани под ней выглядят раздраженными и кровоточат,
- атрофическая: налета очень мало и находится он в трудно доступных местах. Отмечается сильное покраснение неба, горла, спинки языка. Сопровождается ощущением сухости и боли,
- псевдомембранозная: самый распространенный тип. На слизистых оболочках появляются мелкие красные пятна, которые быстро разрастаются в объеме и покрываются белым налетом. Очаги инфекции болезненны.
Признаки грибкового поражения губ
Область губ становится болезненной Грибок на губах, симптомы которого проявляются сразу (острое течение), либо со временем (хроническая форма) имеет общие признаки. К ним относятся:
- белесый налет на внутренней стороне губ;
- кайма губ становится красной;
- область губ становится болезненной, чувствительной, опухает;
- губы становятся стянутыми, подвергаются шелушению.
Грибок кандида имеет отличительный признак, симптом связан с невозможностью удаления белого налета, образующегося внутри губ. При его устранении на поверхности слизистой образуются кровоточащие язвы. Грибок кандида на губах имеет дополнительные специфические симптомы, зависящие от типа недуга.
Симптомы и последствия молочницы
Проявления кандидоза у взрослых и у детей выражаются в схожих симптомах.
- зуд, жжение и сухость в ротовой полости, на губах и горле,
- белые рыхлые бляшки или «молочная» пленка на мягких тканях полости рта – это самый главный и самый специфичный симптом. Как правило, налет имеет творожистую структуру, он исключительно белый или немного желтоватый, так что его сложно перепутать с чем-то другим,
- гиперемия и отек слизистой,
- болезненный и затрудненный процесс глотания: ощущения «комка в горле»,
- общая слабость: причина с интоксикации организма продуктами метаболизма грибков Candida.
Если своевременно не начать лечение кандидоза, течение болезни усугубляется – воспаление затрагивает все большие области, распространяется на миндалины, глотку и пищевод. Грибковые очаги разрастаются, вплоть до образования тонкой пленки, выстилающей всю полость рта.
Молочница губ у новорожденных
Новорожденные дети, несмотря на то, что почти не контактируют с внешними раздражителями, тоже могут заразиться кандидозом. Чаще всего это происходит по вине матери, которая не соблюдает нормы гигиены. Предрасположены к развитию молочницы дети, у которых:
- Постоянно грязные пустышки;
- Редко омываемые бутылочки для воды или молочных смесей;
- Матери не соблюдают нормы личной гигиены (в первую очередь в области груди, ведь ребенок постоянно контактирует с ней во время грудного вскармливания).
Диагностика кандидоза и его дифференцирование
При возникновении вышеописанных симптомов следует обратиться за консультацией к стоматологу. Ведь для того, чтобы диагностировать кандидоз, недостаточно визуального осмотра в зеркале у себя дома. Конечно, врач тоже выполнит осмотр, попутно выслушав жалобы пациента и сведения и сопутствующих заболеваниях. Но для дифференцирования молочницы от других проблем полости рта назначит также ряд анализов – соскоб со слизистой (для высеивания материала и выявления возбудителя), кровь на ПЦР, у взрослых пациентов возьмет анализ крови на сахар.
Заболевания, имеющие ряд общих признаков с кандидозом во рту:
- щелевидное импетиго (стрептококковая заеда),
- эрозивные папулы в углах губ (при сифилисе),
- рецидивирующий герпес,
- афтозный стоматит.
Именно поэтому нужно обязательно обратиться к врачу, а не заниматься самолечением. Каждое заболевание имеет свой возбудитель (грибки, вирусы, микробы), так что и препараты должны назначаться строго определенные.
Лучшие препараты для борьбы с молочницей
Обращаться за подбором медикамента лучше к специалисту. Но можно и самостоятельно выбрать средство для устранения грибка. Обращать внимание нужно в первую очередь на ведущие наименования лекарств:
- «Пимафуцин»;
- «Итракон»;
- «Медофлюкон»;
- «Фуцис».
Пимафуцин
Итракон
Медофлюкон
Фуцис Подробнее о достоинствах и недостатках каждого препарата рассказано ниже.
Пимафуцин
Самый разрекламированный и безопасный препарат для устранения молочницы. Помогает бороться не только с кандидозом на губах, но и с грибком внутри ЖКТ, в половой системе.
Подходит для применения в целях профилактики, так как обладает мягким действием. Список противопоказаний у этого препарата очень мал. Можно пользоваться «Пимафуцином» и во время беременности. В период лактации на предмет продолжения курса следует консультироваться с врачом.
Выпускается в виде капсул,
свеч для введения в половые органы, мазей. Для лечения губ можно приобрести мазь или капсулу. При приеме капсул следует пройти курс длительностью 1 неделю, после чего прекратить или на время отложить дальнейший прием препарата.
Итракон
Препарат обладает двойным действием. Он позволяет устранить все проявления кандидоза, а также микоза – схожего грибкового заболевания. Благодаря этому он рекомендуется пациентом с комплексным заражением грибками. Но у лекарства есть много противопоказаний:
- Аритмия;
- Гиперчувствительность;
- Аллергия на компоненты состава;
- Беременность;
- Лактация.
После приема пациент может испытывать побочные эффекты. Они заключаются в головных болях, головокружениях, изредка – в тошноте и рвоте. При передозировке человек может потерять сознание. Поэтому перед приемом медикамента следует проконсультироваться с врачом.
Фуцис
Достоинство этого препарата – достаточно выпить всего одну таблетку, чтобы полностью избавиться от грибка. Таблетка (единственная форма выпуска лекарства) устраняет грибок в течение недели. По истечении 7 дней организм считается полностью здоровым.
Медофлюкон
Направлено против кандидоза и любых других форм грибков. Именно этот препарат используют для лечения новорожденных, потому что он обладает мягким действием и вводится внутривенно. Если молочница возникла у беременной, перед использованием лекарства следует обратиться к специалисту.
Лечение молочницы полости рта
Основной целью лечения кандидоза является подавление и нейтрализация очагов инфекции, облегчение самочувствия пациента и восстановление слизистой полости рта и глотки. Чтобы вылечить молочницу назначают полоскания с содой, йодинолом, фукорцином и раствором буры. Последний препарат еще известен как – «натрия тетраборат» 20% раствор в глицерине. Многие десятилетия успешно применяется для подавления жизнедеятельности бактерий и грибков, в т.ч. и Candida. Может использоваться и в виде аппликаций на проблемных участках.
Во время лечения нужно соблюдать щадящую диету:
- отказ от продуктов с содержанием дрожжей, сахара, острых и соленых, чрезмерно горячих и холодных, чтобы не травмировать слизистые,
- отказ от газированных и алкогольных напитков,
- употреблять продукты с высоким содержанием витаминов С, РР и В.
Лечение молочницы во рту занимает в среднем 7-10 дней. В легких случаях стоматолог может назначить только местные процедуры в виде полосканий, ротовых ванночек, аппликаций и таблеток для рассасывания, а в среднетяжелых и тяжелых ситуациях не избежать общей терапии – в виде таблеток для приема внутрь. Причем, лечение у детей отличается – ведь малышам нельзя принимать некоторые препараты и полоскать горло груднички еще не умеют. Тут возможны только аппликации для обработки полости рта, реже инъекции в виде уколов, свечей.
Специфика лечения
От кандидоза поможет избавиться только комплексный подход, который включает соблюдение специальной диеты и прием медикаментов, назначенных врачом. Чаще всего применяют следующие противогрибковые препараты:
- Пимафуцин. Избавляет от грибков, локализованных на коже губ и в желудочно-кишечном тракте.
- Медофлюкон. Эффективно борется с разными видами микроорганизмов рода Candida.
- Флуконазол. Используется не только для лечения молочницы, но и для профилактики.
- Низорал. Избавляет от грибковых инфекций, поражающих кожу, ногти, мягкие ткани и желудочно-кишечный тракт.
При необходимости проводятся полоскания рта обеззараживающими растворами. Рекомендуется делать это после приемов пищи, но не чаще 3 раз в день. Зачастую для полоскания используется раствор йодной воды (8 капель йода на 200 мл теплой воды) или марганцовки (1:5000). Очень важно воздействовать на грибок не только внутренне, но и внешне. Для этого нужно регулярно обрабатывать губы антисептиками. В качестве них можно использовать Хлоргексидин, Фукорцин или другие дезинфицирующие средства.
Не стоит забывать, что основной причиной возникновения заболевания является понижение иммунитета. Поэтому необходимо принимать иммуностимулирующие препараты и комплексы витаминов.
Больше значение имеет простая, но действенная диета. Правильно составленный рацион позволяет понизить интенсивность размножения микроорганизмов рода Candida. В период лечения следует отказаться от острых и кислых блюд. Они раздражают воспаленную слизистую оболочку полости рта. Употребление такой пищи вызовет сильную боль и жжение во рту и не понизит скорость заживления ранок. Нужно исключить из рациона продукты, способствующие развитию грибка. К ним относятся:
- алкоголь;
- кофе;
- мучные изделия, которые содержат дрожжи;
- жирные сорта мяса и рыбы;
- сладости, в том числе сладкие фрукты и напитки;
- копченые, острые, соленые и маринованные продукты.
Прием противогрибковых препаратов
Для успешного лечения от кандидозной инфекции в полости рта и минимизации рецидивов болезни необходимо принимать антибиотики (антибактериальные препараты) и пользоваться противогрибковыми мазями. Назначаются они строго врачом, в зависимости от ситуации, поэтому называть конкретные препараты не будем, чтобы не побуждать вас, наши дорогие читатели, к самолечению.
Эффективно действуют полиеновые антибиотики (нистатин, леворин) – природные противогрибковые препараты, разрушающие клеточную мембрану патогенных микроорганизмов. Практически не всасываются в ЖТК и через слизистые, т.е. действуют конкретно на паразитирующий грибок, а не на его носителя-человека.
Еще в терапии используют препараты группы имидазолов (Клотримазол). Они назначаются для местного применения и успешно борются с грибковой инфекцией. В комплексном лечении назначают флуконазолы (Дифлюкан, Флюкостат) – действенные противогрибковые препараты, которые можно применять у детей с рождения.
«С молочницей за 1 год жизни мы столкнулись два раза. И если в первый раз это была белая полоска на языке (я сначала думала, что от молока), то во второй я долго не могла понять, в чем дело – сын плакал во время кормления, но язык был чистым. Потом посмотрела внимательнее и увидела на щеках пятна, как будто творожок. Пришлось покупать лекарство – раствор с клотримазолом, смазывали им пятнышки, пока все не исчезло».
Анастасия З., отзыв с сайта baby.ru
Факторы риска заболевания грибком на губах
Грибки встречаются всюду. При определенных благоприятных для их развития условиях, микотические споры рассеиваются, и грибки размножаются, образуя многочисленные колонии и заселяя все новые и новые ткани. Существуют факторы, которые способствуют процессу:
- пониженный иммунитет;
- перегревание или переохлаждение;
- кандидозный стоматит;
- гормональный сбой;
- эндокринные заболевания (диабет);
- иммунодефицит;
- лечение антибиотиками в течение длительного времени;
- использование чужих косметических средств (помада, гель или карандаш для губ)
- частые стрессы или депрессивные состояния;
- беременность;
- злоупотребление сладким и мучным;
- недостаток витаминов;
- онкологические заболевания и их специфическое лечение;
- не соблюдение правил гигиены при использовании зубных протезов.
Код по МКБ-10
В связи с тем, что недуг поражает многие органы и системы, молочница шифруется по Международной классификации болезней следующим образом:
- В37.0 – Кандидозный стоматит.
- В37.1 – Легочной кандидоз.
- В37.2 – Кандидоз кожи и ногтей.
- В37.3 – Кандидоз вульвы и влагалища.
- В37.4 – Кандидоз других урогенитальных локализаций.
- В37.5 – Кандидозный менингит.
- В37.6 – Кандидозный эндокардит.
- В37.7 – Кандидозный сепсис.
- В37.8 – Кандидоз иных локализаций.
- В37.9 – Кандидоз неуточненный.
Грибок на губах: лечение
Виды комплексной терапии включают:
- Медикаментозное лечение, которое подразделяется на три подгруппы:
- Обезвреживающее (антисептическое) – применяется в самом начале болезни. Основными средствами являются противокандидозные спреи и растворы для обработки кожи и слизистой местного применения, а также таблетки (спрей — орасепт, раствор люголя и хлоргексидина, таблетки — тантум верде и новосепт форте).
- Системное (препараты только для внутреннего применения), например: флуконазол, дифлюкан.
- Местное (использование кремов и мазей): канистен, нистатин.
Внимание! Лечение назначается в соответствии с возрастными и весовыми показателями пациента. Особо аккуратно стоит подходить к лечению, если обнаружена молочница на губах у ребенка.
- Лечение средствами народной медицины, применяемое как вспомогательная терапия в деле искоренения «гадкого» грибка.
Настой из ромашки. Примерно одну столовую ложку сухих цветков аптечной ромашки заварить одним стаканом крутого кипятка. Плотно закрыть банку и укутать на один час. Полученным настоем комнатной температуры с помощью ватного диска промачивать зараженные области гиб. Настой обладает бактерицидным и ранозаживляющим действием.
Настой с зеленым чаем. Способ приготовления и использования такой же, как и с ромашковым настоем.
Отвар из семян календулы и коры дуба. Сырье берут из расчета один к одному. Если это по одной столовой ложке, то воды наливают два стакана. Кипятят на водяной бане в течение тридцати — сорока пяти минут. Остужают и применяют для полоскания полости рта. Процедура снимает воспаление и подсушивает высыпания. Отвар используйте минимум два раза в день.
Содовый раствор. Готовят следующим образом: в одном стакане кипяченой воды растворите одну чайную ложку пищевой соды и хорошо перемешайте. Полощите полость рта дважды в день.
Куркума. Для приготовления «целебного зелья» применяются измельченные корни растения. Порошок куркумы соединяют с теплым молоком до получения плотной кашицы. Средство отлично зарекомендовало себя как антибактериальная помощь при угловом хейлите. Манипуляцию проводите ежедневно.
Что это за болезнь?
Молочницей называют одну из разновидностей грибкового заболевания, вызываемого грибками рода Candida.
Принято думать, что оно поражает лишь женщин, однако дети и представители мужского пола также страдают недугом. Он может протекать с ярко выраженными симптомами либо в скрытой форме. Если больной не лечит молочницу, она приобретает хроническое течение, которое чревато появлением осложнений. Вот почему специалисты стремятся своевременно обнаружить кандидоз и назначить терапию.
Псевдомембранозная форма
Наблюдается в самом начале развития болезни. Проявляется появлением налета белого оттенка. Он возникает на небе и других участках слизистой оболочки. Сначала выглядит как белые крупинки, со временем возникает творожистая пленка. Очаги начинают сливаться в один большой, покрывая полностью рот, глотку и губы. Боль не беспокоит. Может возникать лишь при травмировании болезненного участка.
Эта форма чаще всего возникает у людей, которые больны СПИДом. Лечению она практически не поддается. Пленку трудно удалить. Под ней находятся язвы, раны и эрозии.
Рекомендации специалистов
Чтобы ускорить процесс выздоровления необходимо придерживаться рекомендаций. Также эти советы отлично подойдут для профилактики грибка, обладающего рецидивирующим характером:
Питание
Рацион должен быть обогащён белком и клетчаткой, а об употреблении сладостей, кислых и сильно соленых блюд не может быть и речи, потому что они являются благоприятной средой для размножения бактерий. Употребляйте больше кисломолочных продуктов, они уничтожают патогенные бактерии.
Консультация
Нельзя самостоятельно выписывать себе лекарства, так как они имеют много противопоказаний и будут эффективны не для всех. Также, следует забыть о лечении народными методами от бабы Нюры. Нужна консультация специалиста.
Наиболее эффективно лечение в комплексе с медикаментами и мазями.
Курение
Для скорейшего выздоровления необходимо будет искоренить эту привычку, так как пагубное воздействие никотинового дыма на поверхность губ только усугубит течение заболевания.
Гигиенические средства
Категорически запрещено использовать зубные пасты с агрессивным составом (антисептические, отбеливающие средства). Они раздражают слизистую оболочку рта и провоцируют грибок.
Помимо этих рекомендаций необходимо следить за собой и не облизывать губы на морозе, стараться их мазать вазелином или специальным увлажняющих средством. Не целоваться с людьми, у которых ярко выражена грибковая инфекция на губах, а также регулярно посещать стоматологическую клинику.
Диагностика
Чтобы правильно распознать какой недуг упорно хочет захватить вас, необходимо проконсультироваться у врача – дерматолога. А также:
- пройти детальный осмотр пораженного органа;
- сделать соскоб с пораженных участков кожи или слизистых (для рассмотрения под микроскопом, чтобы определить род грибковой инфекции);
- провести посев на питательную среду (для определения чувствительности грибка к определенным препаратам);
- сделать общий и биохимический анализ крови (для подтверждения нахождения грибковой в инфекции в организме).
Молочница: почему усиливается от антибиотиков
Прием антибиотиков может спровоцировать появление молочницы у человека. Часто это возникает при неправильно подобранной терапии, длительном курсе, самостоятельном назначении дозы медикаментов.
Антибиотики способны не только бороться с болезнетворными микроорганизмами. Они губительны и для естественной микрофлоры человека.
В результате, у женщин появляется дисбиоз – нарушение состава нормальной микрофлоры влагалищной среды.
Если иммунная система человека сильная, прием антибиотиков никак не повлияет.
Снижение защитных функций организма является благоприятным фактором для размножения грибка.
Если гинеколог констатирует у пациента молочницу после приема антибиотиков, назначаются препараты, которые:
- Восстанавливают микрофлору;
- Повышают защитные функции иммунной системы;
- Восполняют дефицит витаминов.
После проведенного восстановительного лечения, необходимо сдать повторный анализ.
Спрей Эпиген Интим
Во время беременности я задумалась про молочницу и ее лечение, хотя симптомы молочницы у меня и не проявлялись, т.е. я была здорова, однако в связи с постоянным хроническим течением заболевания ранее, я решила поискать средство для профилактики, которое разрешено применять при беременности. Мой лечащий врач посоветовал Спрей Эпиген Интим. Описывал средство как универсальное, лечить такие «бяки» как герпес, папилломы, молочницу, бактериальный вагиноз, кондиломы и т.п.
В аптеке я была в шоке от цены Эпиген Интим, она огромная. В моем случае 60 мл. средства мне обошлись в районе 1200 рублей. Хотя знаю, что продается средство в фасовке по 15 мл. и соответственно стоит дешевле.
Продается Спрей Эпиген Интим в картонной упаковке, где расположен пластиковый флакон с насадкой распылителем и подробнейшая инструкция. Насадка-распылитель постоянно подтекала у меня, хотя мне, может, попался брак, однако именно это я считаю недостатком изделия, постоянно грязные руки и необходимость тщательно мыть флакон, а потом протирать его спиртом, хотя я спиртом и так протирала перед применением, так как насадка распылитель не имеет защитного колпачка.
Жидкость слегка маслянистая темно-коричневого цвета.
Активным действующим компонентом Эпиген Интим является корень солодки голой, который в восточной медицине по целебным свойствам занимает первое место, причем именно противовоспалительное свойство солодки и является самым ценным качеством в этом растении. Солодка подстегивает иммунитет, повышает сопротивляемость организма, стимулирует выработку интерферона, действует на патогенные организмы и оказывает регенерирующие воздействие.
Применение Спрей Эпиген Интим простое, необходимо вставить насадку распылитель во влагалище и нажать 1-2 раза, использовать можно 1-2 раза в день. В качестве профилактики нужно применять Эпиген Интим после каждого полового акта. Так как беременность не является противопоказанием для занятий сексом, то мы с мужем вели активную жизнь в этом плане, и я пользовалась спреем каждый раз после полового акта, как раньше использовала Мирамистин, а муж продолжал пользоваться Мирамистином.
Эпиген Интим можно пользоваться на протяжении всей беременности, что очень удобно, противопоказанием является лишь повышенная чувствительность, что у меня, например, не наблюдалось.
Во время беременности мне не довелось лечить молочницу спреем Эпиген, однако у меня на губах выскочила малярия или герпес и вот ее я лечила этим средством. Помимо таблеток, которые я принимала вовнутрь, я каждый день до 4 раз в день прыскала на губу с болячкой спрей и давала высохнуть. Единственно необходимо следить, чтобы жидкость с малярии не растекалась по не зараженным участкам кожи, а то у меня получилось перенести болячку с губы на щеку. Я обкладывала малярию ватными дисками и только после этого прыскала Эпиген.
Как уже писала, недавно у меня произошел рецидив молочницы, и сначала я попыталась полечить ее спреем Эпиген. Увы, зуд и жжение проходили на несколько часов, а потом все возвращалось, пришлось использовать свечи Пимафуцин и Виферон. Как профилактическое средство от молочницы Эпиген просто незаменим, так как во время беременности этой «бяки» у меня не было, а вот как единственное средство для лечения не очень подходит. Хотя в защиту скажу, что неприятные симптомы, такие как зуд и жжение убирает уже через 5 минут и хватает эффекта на 4-6 часов, что в принципе удобно, пока лечишься свечами от молочницы. Особенно хочется отметить, что спрей Эпиген безопасен для матери и ребенка, особенно при лечение герпеса, который в основном лечится тяжелыми таблетками, которые могут оказать влияние на плод.
Конечно, цена Эпиген Интим высокая, но флакона мне, например, хватило на 17 месяцев и там еще что-то осталось, так, что могу, смело сказать, что на 1.5 года лекарственного средства точно хватит.
Вот нашла на просторах интернета, смотрим, интересно:
Риски заболеть
Грибы Кандида — естественные обитатели микрофлоры человеческого организма. Поэтому вероятность заразиться молочницей есть всегда. Однако ввиду физиологических особенностей женщины подвергаются большему риску заболеть кандидозом, чем мужчины. Выше вы можете видеть симптомы вагинальной молочницы у женщин.
Опасность заболевания
Трещины на губах свидетельствуют о грибковой инфекции, которая в скором времени может сказаться на других органах. При отсутствии лечения кандида проникает в кровеносные сосуды, в результате чего возникают кровотечения.
Кандидоз очень быстро распространяется, поэтому высокая вероятность попадания грибка с области губ в слизистую оболочку рта и перерасти в опухоль, а затем и в онкообразование
Курящие люди больше всего подвержены риску, так как они ежедневно подвергают губы негативному влиянию дыма. В результате может измениться форма губ и возникнут раковые опухоли.
Грибок под ногтями на руках. Лечение
Внешние особенности
Чтобы получить эффективное лечение молочницы на губах, нужно вовремя заметить болезнь. Поэтому важно уметь распознавать проблему и отличать ее от герпеса. На сегодняшний момент выделяют три вида молочницы:
- Стоматит. Эта форма кандидоза вызывает появление язв. Они формируются на внутренней стороне. Во время приема пищи возникает боль, дискомфорт.
- Заеды. Вид молочницы образуется в уголках рта. Как правило, страдает лишь определенная область губ. Во время еды образования болят и мешают. Такой кандидоз появляется при травмах, полученных во время осмотра у стоматолога. Нередко от этой молочницы страдают дети, которые любят сосать пальцы. В зоне риска пациенты с неправильным прикусом.
- Хейлит. Данная форма схожа с герпесом. У пациента страдает нижняя губа. Появляются пятна, налет и пузырьки с жидкостью.
У каждого человека болезнь может протекать совершенно по-разному. У некоторых возникает лишь одна форма, у других – сразу три. У пациента может появиться чувство жжения. Во время приема пищи и разговоре это ощущение усиливается. Спустя время, на щеках, губах, языке появляется налет белого цвета. Под ним формируются язвы. Если на этом этапе не оказать медицинскую помощь, то слой станет плотнее и станет похож на творожистую массу. Если пациент захочет счистить его, пойдет кровь. Даже во время приема пищи пораженный очаг может кровоточить.
Важно сразу обратиться к врачу. Он сможет подобрать правильное лечение и предотвратить осложнения. Если болезнь запустить, то грибок опустится ниже. Это чревато проблемами с пищеводом, гортанью и желудком. В итоге у мужчин возникнет кандидоз простаты, у женщин – молочница на половых губах.
Кандидозная паронихия у женщин: симптомы
Кандидоз ногтей встречается в основном у женщин из-за:
- Частого мытья посуды;
- Приготовления пищи;
- Стирки;
- Маникюрных манипуляций, которые повреждают кожные покровы.
Симптомы кандидозной паронихии проявляются не сразу.
Первые признаки:
- Появляется покраснение кожной складки, которая окружает ногти;
- Кожа вокруг ногтевой пластины отекает;
- Наблюдаются трещины и гнойники, которые легко лопаются от касания, вызывая боль;
- Меняются форма и структура ногтя.
В случае, если данные симптомы были проигнорированы, отсутствовало лечение, кандидозная паронихия переходит в хроническую стадию. Она характеризуется отхождением ногтевой пластины, наличием неровностей и изменением цвета ногтя.